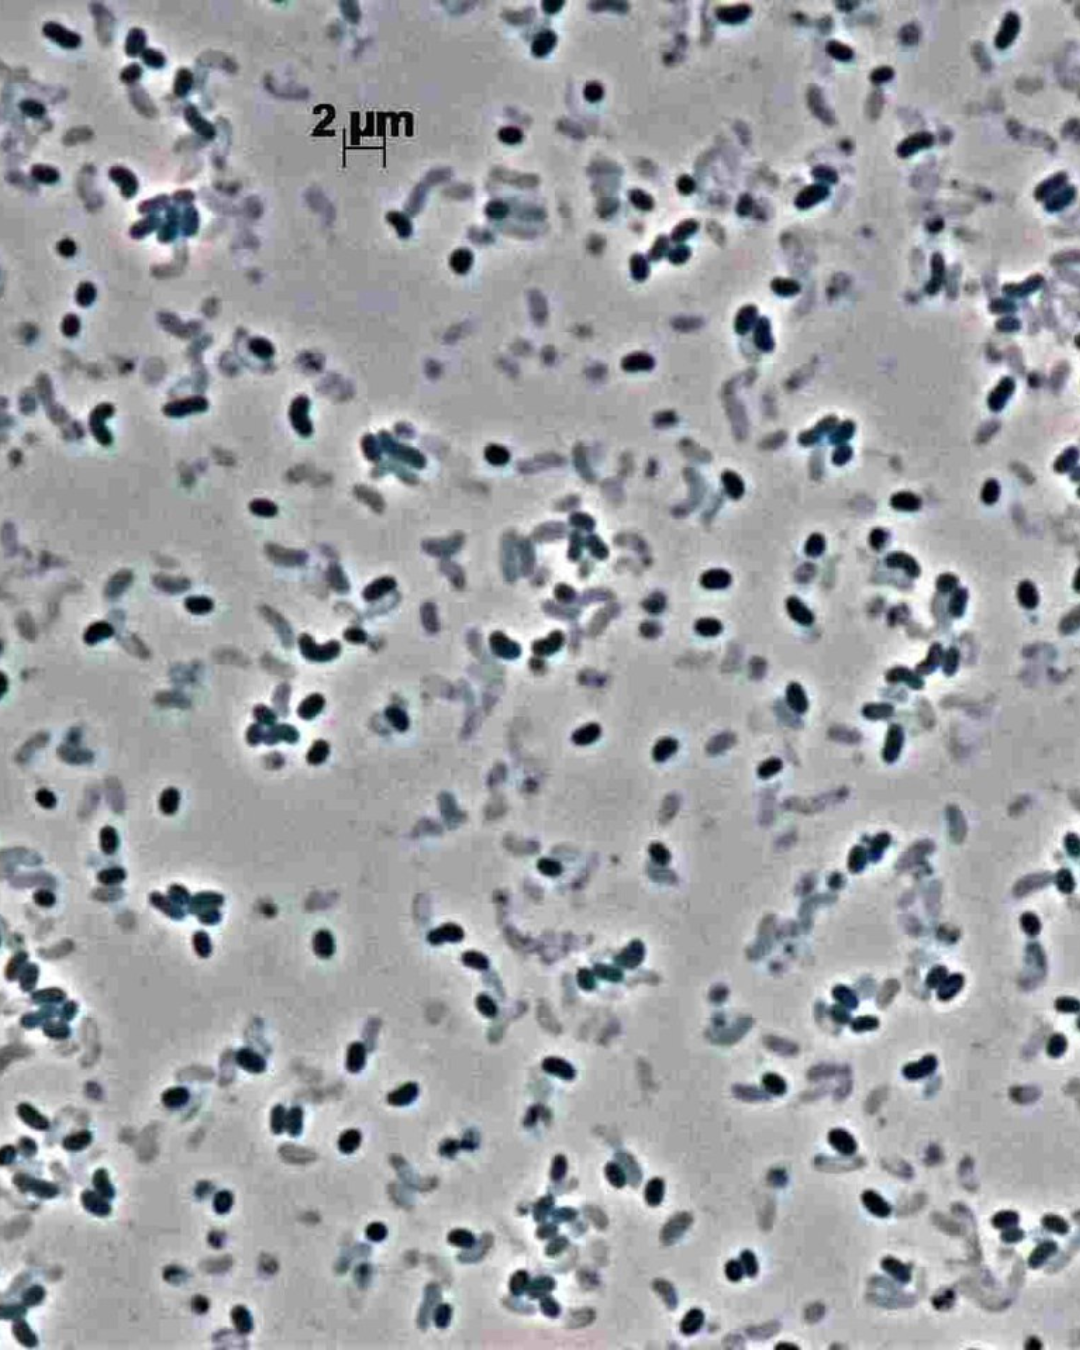

WHAT IS MARINE BIOPROSPECTING?
Uncovering the ocean’s hidden treasures through bioprospecting
Bioprospecting is the exploration of natural sources for small molecules that could be developed into commercially valuable natural products. Currently, most natural products have resulted from terrestrial organism-focussed bioprospecting. Yet, considering that the marine environment covers more than 70% of the Earth and is still largely unexplored, marine organisms represent an untapped resource for sustainable exploration and may reveal a variety of molecules with biotechnological applications.
What kinds of applications are there?
Marine bioprospecting unlocks nature’s chemical library, but its real impact is creating tangible solutions. Discoveries from the sea are being translated into innovative products across key sectors.
The journey from ocean discovery to market demonstrates a powerful cycle of innovation with immense societal value.

Drug discovery
For cancer therapy

Nutraceuticals
As natural additives in foods
Sustainable aquaculture
Through pharmaceuticals

Agrochemical products
Biostimulants and biopesticides
LETS DIVE INTO DIFFERENT EXAMPLES
How can marine bioprospecting lead to new drug discoveries?
The story of halaven…
… began with the discovery of halichondrin B, a potent molecule from a rare sea sponge that disrupts cancer cell division. However, harvesting it from nature was unsustainable. Scientists embarked on a decades-long quest to synthetically recreate its complex structure in the lab, leading to a pivotal discovery: only a specific fragment of the original molecule was responsible for its anticancer power. This breakthrough enabled the creation of eribulin mesylate — a simplified, fully synthetic, and manufacturable drug.

Clinical impact and legacy:
1. In a trial of 762 women with metastatic breast cancer, Halaven extended overall survival by a significant 25% compared to other treatments.
2. It is now a crucial chemotherapy for advanced breast cancer and liposarcoma, helping to slow disease progression and extend lives.
3. The drug stands as a landmark achievement, demonstrating how marine biodiversity can inspire the design of innovative, life-saving medicines.

Can marine organisms be used to develop nutraceuticals and functional foods?

The discovery of astaxanthin…
… began when it was identified as a potent red pigment in microalgae and marine life. As one of nature’s strongest antioxidants, it showed great potential for combating oxidative stress, but natural harvesting was unsustainable. Scientists overcame this by perfecting controlled cultivation, using stress triggers to make Haematococcus pluvialis microalgae produce high concentrations of astaxanthin through biofermentation
Health benefits and commercial impact:
1. Extensive research confirmed significant benefits, including a 40% reduction in inflammatory markers, increased skin resistance to UV damage, and improved muscle recovery.
2. The purified compound is now stabilized into bioavailable forms such as softgels, oils, and powders.
3. Today, astaxanthin is a top-selling marine nutraceutical, widely used in dietary supplements, cosmetics, and functional foods for natural preventive health and wellness support.

What about the discovery of new pharmaceuticals for sustainable aquaculture?
The development of a vaccine against vibrio bacteria…
… emerged as a critical response to disease outbreaks in intensive aquaculture, where antibiotic overuse was causing resistance and pollution. Scientists isolated safe bacterial antigens and employed recombinant DNA technology, using yeast to produce the vaccine at scale without the pathogen itself.

Efficacy and sustainable impact:
1. Field trials on salmon farms demonstrated that vaccination reduced mortality by over 85% and cut antibiotic use by up to 90%.
2. Vaccinated fish exhibited better growth rates and lower stress, improving overall welfare.
3. The vaccine is now a cornerstone of global aquaculture, enabling cleaner production, reducing environmental impact, and ensuring food safety, a prime example of biotechnology driving sustainable animal protein production.

How can marine bioprospecting contribute to develop new bioestimulants and biopesticides for agriculture?

The application of seaweed extracts in agriculture originated from…
… coastal observations, where crops treated with brown seaweed showed improved resilience. Scientists identified the key bioactive compounds, such as polysaccharides and natural plant hormones, responsible for stimulating growth and activating the plant’s own defense systems
Efficacy and global adoption:
1. In field trials on tomato crops, the extracts led to a 20% yield increase, a 30% reduction in nitrogen fertilizer use, and a over 50% drop in fungal infections like Botrytis.
2. The processed extracts are formulated into user-friendly liquids or powders for foliar or soil application, suitable for both organic and conventional farming.
3. Today, these marine-derived solutions are used on millions of hectares globally, from vineyards to rice fields, demonstrating how nature-based innovations can enhance crop resilience and reduce dependence on synthetic chemicals.

HOW IMPORTANT IS IT?
Unlocking critical biofrotiers
Marine bioprospecting is a critical frontier in biotechnology, unlocking the chemical diversity of the ocean to address pressing global challenges in health, agriculture, and sustainability. By exploring marine organisms and their unique adaptations, we not only discover novel compounds for medicines, nutraceuticals, and agrochemicals but also reinforce the intrinsic value of marine biodiversity, promoting its conservation and sustainable use.
Type of organisms used in marine bioprospecting
Marine bioprospecting explores a wide range of organisms, each adapted to survive in harsh environments and offering unique bioactive compounds, such as:

Sponges, tunicates & soft corals
Sources of anticancer and antimicrobial agents.

Microalgae & cyanobacteria
Renewable sources of antioxidants, pigments, and biofuels.
Marine fungi & bacteria
Producers of novel enzymes and pharmaceuticals.

Bryozoans & mollusks
Have also contributed valuable molecules to drug discovery.
Where can they be found?
Coral reefs
often called “marine rainforests,” which host immense biodiversity and complex symbiotic relationships
Deep-sea hydrothermal vents
where bacteria and invertebrates thrive under high pressure, temperature, and chemical toxicity.
Polar regions
home to psychrophilic (cold-adapted) organisms producing antifreeze proteins and cold-active enzymes.
Mangrove forests and seagrass beds
which shelter diverse microbial and invertebrate communities in fluctuating salinity and oxygen conditions.
Marine sediments and coastal rock pools
rich in microbial life adapted to stress and competition.
Sandy and Muddy Intertidal Flats
in sheltered coastal areas like bays and estuaries.
Link to biodiversity conservation
Marine bioprospecting and biodiversity conservation are mutually reinforcing. Discovering valuable compounds creates a direct incentive to protect marine ecosystems by:
1. Demonstrating the tangible “biovalue” of species, supporting the creation of marine protected areas.
2. Promoting sustainable harvesting practices and habitat restoration.
3. The field itself operates under frameworks that prioritize sustainability and equity, such as: non-destructive sampling and genetic resource banking.
4. Adherence to the Nagoya Protocol, ensuring fair benefit-sharing with source countries.
HOW TO DO MARINE BIOPROSPECTION?
The science behind the discovery: key steps in marine bioprospecting
Transforming a microorganism from the ocean into an innovative biotechnological application is a fascinating and rigorous process. It involves a series of carefully orchestrated scientific steps, guiding researchers from the discovery of an organism in its natural habitat to the creation of a product with tangible value for society. Below, discover the main stages of this research pipeline, which combines cutting-edge technology with a deep understanding of marine biodiversity.
Step 1
Genomics
Genomics is like reading the instruction manual of life – it’s the study of an organism’s complete set of DNA, including all its genes. In marine microbes, this DNA holds the blueprint for creating unique and valuable compounds, like natural medicines or eco-friendly materials.
By using advance DNA sequencing, scientists may find new genetic combinations (called Biosynthetic gene clusters – BGCs) that produce useful substances. It’s like searching for treasure maps inside tiny ocean organisms and unlocking nature’s secrets for health, agriculture, and more!
Step 2
Biomass production
Biomass production is like farming tiny ocean superheroes! Scientists collect marine microbes – tiny organisms like bacteria or algae – and grow them in special tanks or bioreactors under carefully controlled conditions, just like how farmers grow crops (but on a much smaller scale).
These microbes are nature’s tiny factories. When given the right nutrients, light and temperature, they multiply rapidly, creating biomass – a dense, living material full of useful compounds. This biomass can be turned into things like biofuels, natural medicines, or eco-friendly plastics.
Step 3
Chemical extraction
Think of chemical extraction as making a strong cup of tea from marine biomass – instead of tea leaves, we use tiny ocean organims, and instead of flavour, valuable natural compounds are extracted.
Scientists take the biomass and break it down to release such compounds, using special liquids called solvents. These extracted substances could either become: 1) new medicines to fight diseases; 2) natural alternatives to plastic packaging; or even 3) cleaner fuels for a greener future.
The best part? EUREMAP’s methods work for small lab experiments all the way up to large industrial batches. Partner universities and research teams bring their expertise to make this process efficient and effective, helping turn ocean microbes into tomorrow’s breakthroughts.
Step 4
Bioassays and bioprofiling
Imagine finding a mysterious key (in this case a new compound) – bioassays help us discover what doors it can open. In this step several marine compounds are tested, it’s like giving nature’s molecules a job interview: can they fight germs? protect cells? stop cancer? help plants grow? and so on.
The star performers might become tomorrow’s medicines or eco-friendly crop protectors, so they need to get a full “background check” (that’s bioprofiling) to understand exactly how they work, in order to further on capitalise on their biomechanisms.
Step 5
Chemical profiling
Think of chemical profiling as creating a detailed ID card for each marine compound we discover. Scientist use powerful tools to decode the exact molecular makeup of these natural substances – like reading their unique fingerprints.
This process reveals everything about a compund’s structure and properties. Through wich we can answer with process if this specific molecule is similar to any other known molecules or if it has some special potencially useful feature.
The knowledge we gain builds a drowning library of marine compounds. This database becomes a treasure map for future discoveries, potencially leading to new medicines, sustainable materials, or green chemestry solutions.
Step 6
Purification and structure elucidation
Think of purification like panning for gold in a muddy river. We start with a mix of marine compounds and carefully separate them until we isolate the pure, valuable molecules. Once we remove the “dirt” we get the “gold nuggets” of bioative compounds.
Then scientists have to investigate the unique structure of each molecule, this strcuture elucidation reveals exactly how the compound is built at the atomic level, helping them to understand its potencial uses.
The pure, well-understood marine compounds become the foundation for future applications. By perfecting nature’s designs the building blocks for a greener future easily uncover themselves.
Step 7
Purification and structure elucidation
Nature provides incredible molecular blueprints, but sometimes we can improve them. Think of it like renovating a house – we might keep the core structure (semi-synthesis) or build semething entirely new inspired by nature’s designs (synthesis).
Scientists carefully modify marine-derived molecules to make them more effective, stable, or suitable for specific applications. This molecular craftsmanship could lead to better medicines, sustainable materials, and innovative solutions that combine nature’s wisdom with human creativity.
Step 8
Fair data
Just as a lighthouses guide ships through dark waters, FAIR Data principles illuminate research paths for scientists worldwide. At EUREMAP, we transform raw data into beacons of knowledge by applying the following principles:
Findable – Data has unique, persistent identifiers (like DOI) and rich metadata makes it discoverable by search tools
Accessible – Retrievable via standardized protocols, plus the metadata remais available even if data is protected
Interoperable – Uses common languages and links to related data across disciplines
Reusable – Detailed provenance and usage licenses and also meets domain-relevant community standards
This systematic approach transforms isolated data points into a living, interconnected ecosystem. A chemist in Norway can build on antimicrobial data from Portuguese deep-sea samples. A materials scientist in Italy might cross-reference Mediterranean sponge compounds with Australian coral studies. Future researchers will rediscover our work like archaeologists studying ancient ship logs – with fresh perspectives and better tools.
WHAT IS THE ROLE OF RESEARCH INFRASTRUCTURES?
The connective backbone of the pipeline
Modern scientific discovery relies on Research Infrastructures (RIs) — organisations that provide the research community with specialised facilities, resources, and services to accelerate innovation and tackle global challenges.
EUREMAP is powered by a powerful collaborative network of Europe’s leading RIs. Together, these infrastructures form the ideal ecosystem for marine bioprospecting, combining biodiversity, chemical screening, data analysis, and molecular research.
EMBRC
(European Marine Biological Resource Centre)
A distributed infrastructure providing access to marine organisms, ecosystems, and state-of-the-art experimental facilities across Europe, forming the biological foundation for marine bioprospecting.
EMBL
(European Molecular Biology Laboratory)
Europe’s leading life sciences laboratory, driving the molecular understanding of marine discoveries through cutting-edge research, world-class bioinformatics, and vast biomolecular data resources.
EU-OPENSCREEN
The European chemical biology and early drug discovery network, offering integrated access to high-throughput screening, medicinal chemistry, and compound libraries to identify and optimise bioactive molecules from marine sources.
ELIXIR
The European life sciences data infrastructure, enabling researchers to securely store, share, access, and analyse complex biological data, turning marine genomic and chemical information into actionable knowledge.
Power to transform research
The transformative power of Europe’s Research Infrastructures lies in their unique ability to connect, standardise, and translate marine science. They are the essential catalysts that convert potential into discovery, operating through three key principles:
Enabling collaboration and access
A core mission of RIs is to break down barriers. They act as open-access portals for researchers across Europe and beyond. This democratizes science and accelerates discovery by pooling Europe’s distributed resources.
Guardians of standardization and FAIR data
RIs champion the FAIR Data Principles, often providing the digital repositories and data management platforms that turn individual results into a connected, searchable, and reusable library of marine compounds and their properties. This creates a lasting legacy of knowledge for future generations.
From discovery to innovation
By offering a seamless, integrated pathway from sample to data, RIs drastically reduce the time and cost of early-stage discovery. In this way, RIs are critical bridges that translate fundamental marine science into real-world applications for medicine, agriculture, and sustainable industry.
